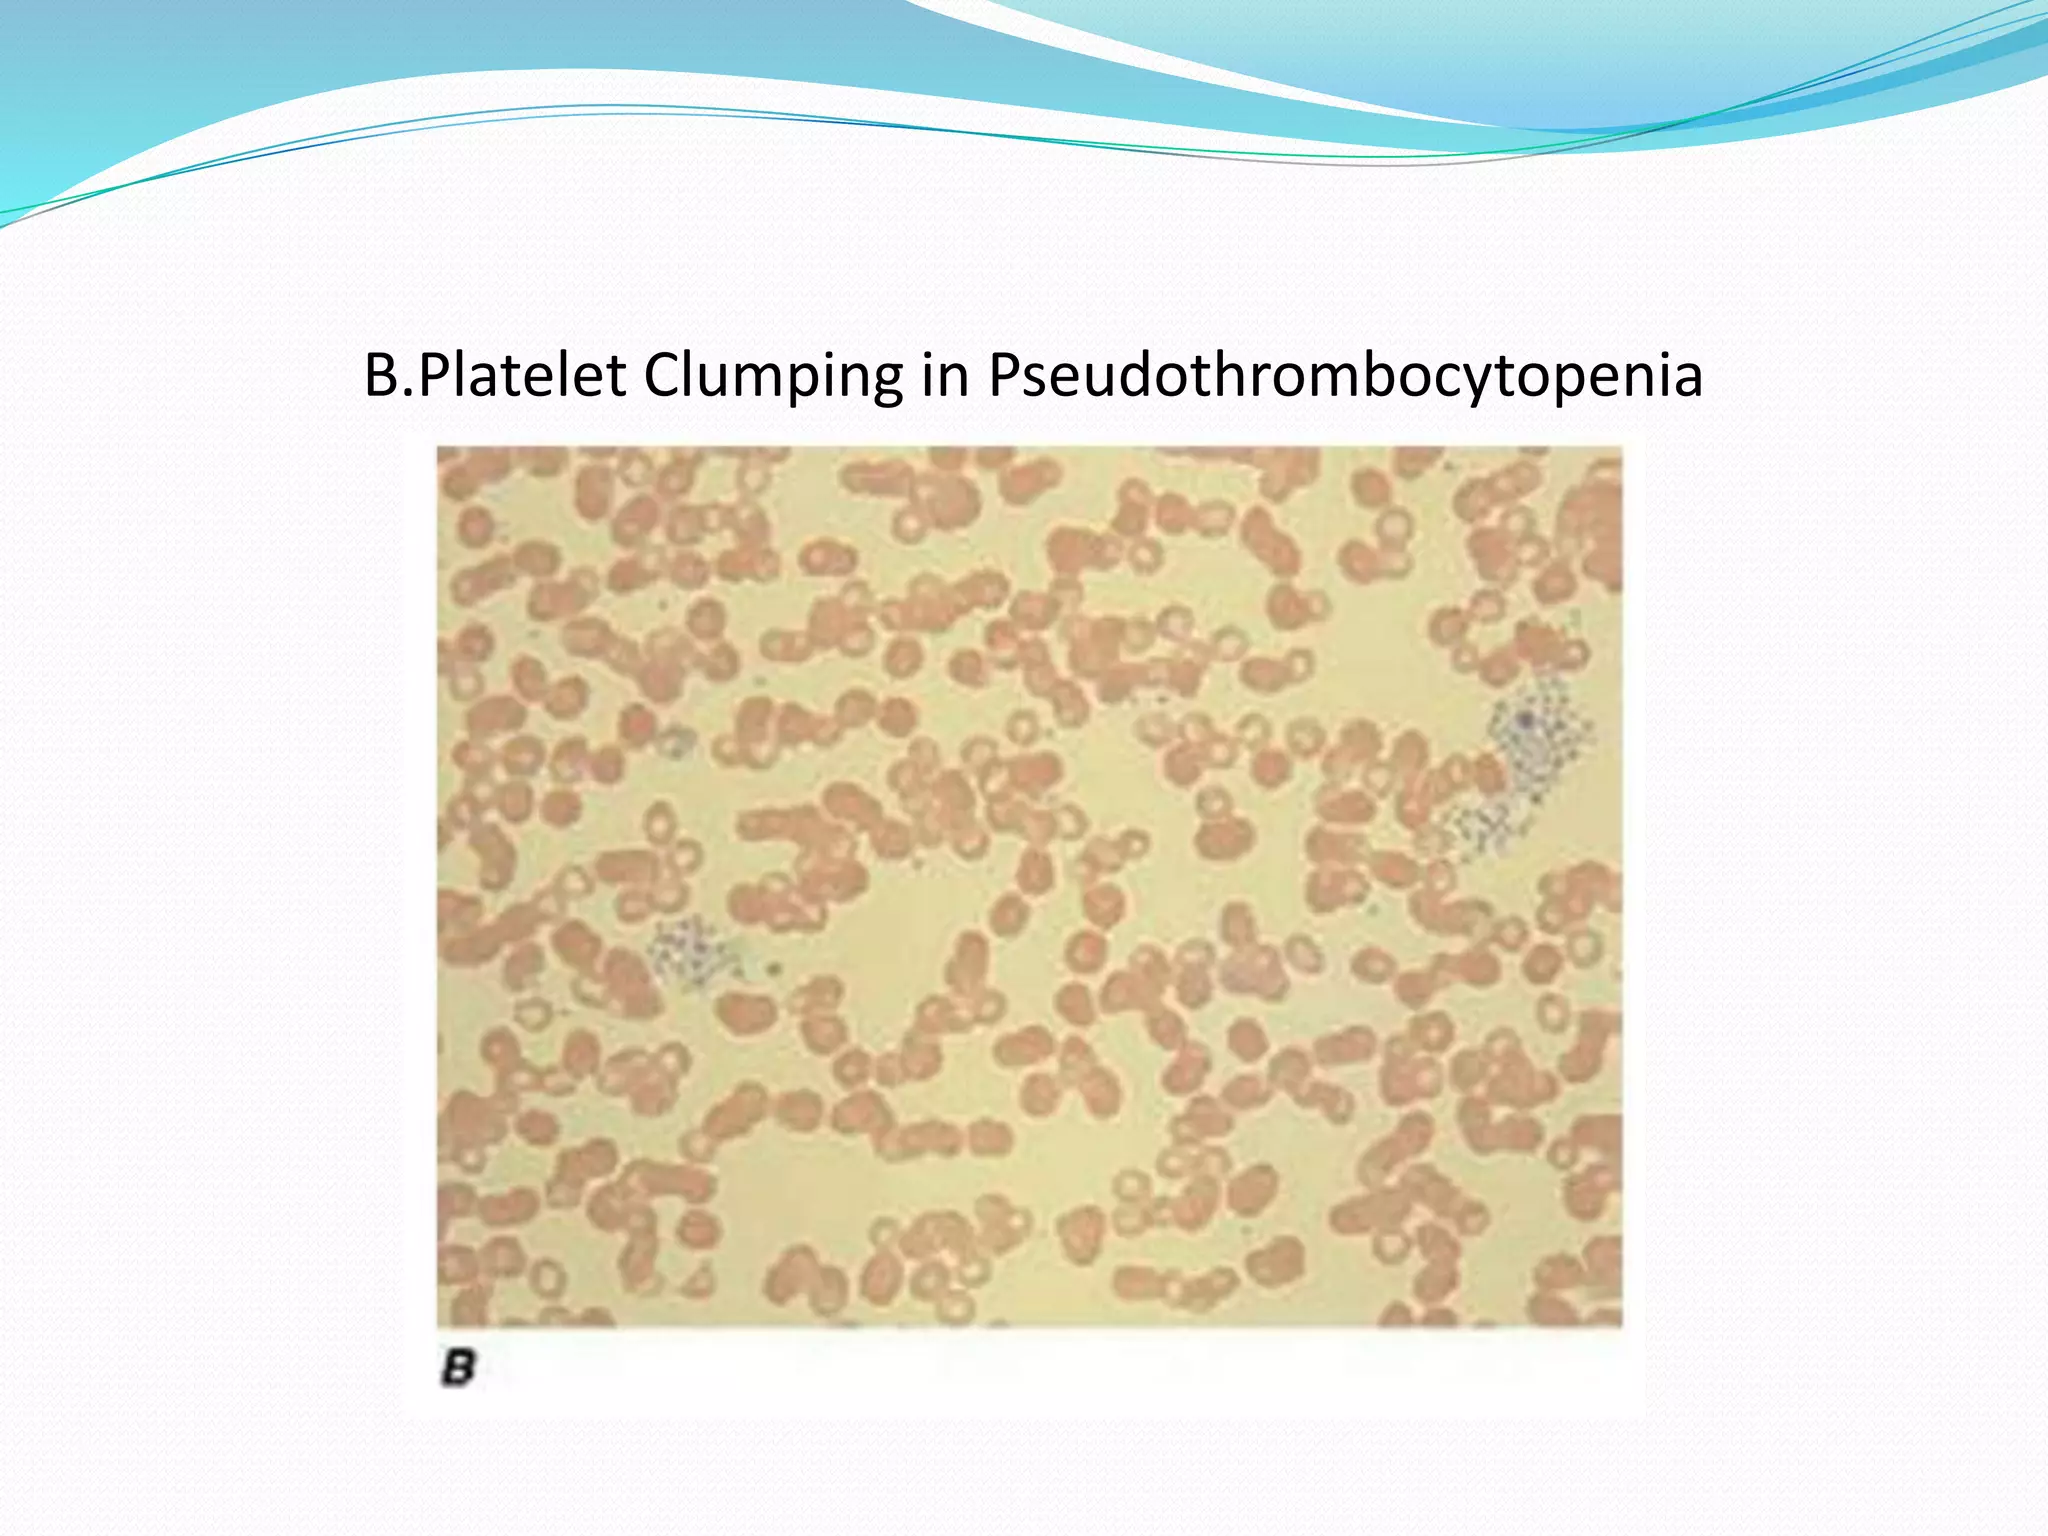
B.Platelet Clumping in Pseudothrombocytopenia

The document discusses essential aspects of platelets, including production, lifespan, and regulation through thrombopoietin. It delves into thrombocytopenia and its causes, such as infections and drug interactions, highlighting various forms of immune thrombocytopenic purpura and their treatments. Additionally, it covers thrombocytosis, qualitative disorders of platelet function, and von Willebrand disease, outlining clinical presentations, diagnostic measures, and treatment strategies.

![Nasal Spray dDAVP
Hemophilia A and mild-to-moderate von Willebrand
disease (type 1):
Intranasal (using high concentration spray [1.5
mg/mL]): <50 kg 150 mcg (1 spray);
>50 kg: 300 mcg (1 spray each nostril);
Repeat use is determined by the patients clinical
condition and laboratory profile.
If using preoperatively, administer 2 hours before
surgery.](https://image.slidesharecdn.com/subjectseminar-approachtopatientwithplateletdisorders-200805171046/75/Approach-to-patient-with-platelet-disorders-64-2048.jpg)


